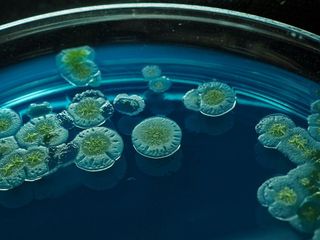

Votre étude sur devis
Vous ne souhaitez pas passer par le ecommerce de notre site ? Vous pouvez faire votre demande directement par mail en nous précisant la ou les études souhaitées. Un devis vous sera envoyé sous 48h. À réception du paiement, la ou les études vous seront transmises sous 24h.